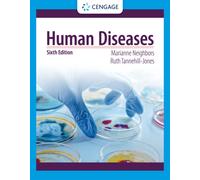
Human Diseases

£113.03
Amazon-marketplace.co.uk
Free Delivery

£177.48
Amazon-marketplace.co.uk
Delivery from £7.74

Human Body Parts & Diseases Word Search Puzzle Book: Word Search with Easy to Read Print on Human Body System, Anatomy, Organs & Illnesses | 6x9 ... have fun with friends or just as a gift
£5.99
amazon.co.uk
Delivery from £2.99

£107.99
amazon.co.uk
Free Delivery

ILLNESSES Crossword: DISEASES VIRUS BACTERIES PATHOGEN | About human diseases, bacteries and a lot more .. | Easy to read | 55 Puzzles | Puzzles for ... and Free Times | 6x9 inches | 110 pages
£6.00
amazon.co.uk
Delivery from £2.99

Probiotics in The Prevention and Management of Human Diseases : A Scientific Perspective
£122.55
Whsmith.co.uk
Free Delivery

Infectious Diseases: A Human History of the Deadliest Diseases and the Battles to Defeat Them
£10.53
amazon.co.uk
Free Delivery

£69.34
Amazon-marketplace.co.uk
Delivery from £7.74

£63.48
Amazon-marketplace.co.uk
Delivery from £2.99

£18.93
Amazon-marketplace.co.uk
Delivery from £0.99

£14.19
Amazon-marketplace.co.uk
Delivery from £2.80

£40.21
amazon.co.uk
Free Delivery

£15.78
amazon.co.uk
Free Delivery

£10.99
amazon.co.uk
Free Delivery

£20.75
amazon.co.uk
Free Delivery

Anatomy Model for Eye Diseases Study, 6X Human Organs Teaching Prop
£36.19
Amazon-marketplace.co.uk
Free Delivery

Can You Catch A Cold?: Untold History & Human Experiments
£28.16
amazon.co.uk
Free Delivery

Anatomy Model for Eye Diseases Study, 6X Human Organs Teaching Prop
£22.79
Amazon-marketplace.co.uk
Free Delivery

The Human Cost of Long Covid: A Doctor’s Journey Through Illness, Loss and Recovery
£18.74
amazon.co.uk
Free Delivery

Anatomy Model for Eye Diseases Study, 6X Human Organs Teaching Prop
£78.69
Amazon-marketplace.co.uk
Free Delivery

Unraveling the Enigma of the Human Mind: Exploring the Complexities of the Human Brain: A Fascinating Journey into the Mind's Mysteries.
£14.93
amazon.co.uk
Free Delivery

Anatomy Model for Eye Diseases Study, 6X Human Organs Teaching Prop
£21.99
Amazon-marketplace.co.uk
Free Delivery

Cracking the Mystery of the Human Brain: Unveiling the Secrets of the Most Complex Organ in the Body for a Better Understanding of Ourselves.
£15.01
amazon.co.uk
Free Delivery

Anatomy Model for Eye Diseases Study, 6X Human Organs Teaching Prop
£13.99
Amazon-marketplace.co.uk
Free Delivery

Pathologic Basis of Disease: A Comprehensive Guide to Disease Pathogenesis, Molecular and Cellular Mechanisms, Morphology, Tumor Biology, and Diagnostic Advances in Human Health
£74.72
amazon.co.uk
Free Delivery

Anatomical Skin Model Human Skin Structure Anatomy Model Medical Teaching for Diseases Study Medical Lecture Report Skin Tissue Structure
£63.89
Amazon-marketplace.co.uk
Free Delivery

Pathologic Basis of Disease: A Comprehensive Guide to Disease Pathogenesis, Molecular and Cellular Mechanisms, Morphology, Tumor Biology, and Diagnostic Advances in Human Health
£97.89
amazon.co.uk
Free Delivery

Anatomy Model for Eye Diseases Study, 6X Human Organs Teaching Prop
£22.29
Amazon-marketplace.co.uk
Free Delivery

3B Scientific Human Anatomy - Diseases of the Middle Ear Chart, Laminated Version
£27.59
amazon.co.uk
Free Delivery

Anatomy Model for Eye Diseases Study, 6X Human Organs Teaching Prop
£50.19
Amazon-marketplace.co.uk
Free Delivery

3B Scientific Human Anatomy - Rheumatic Diseases, Laminated Version
£17.67
amazon.co.uk
Delivery from £4.49

Anatomy Model for Eye Diseases Study, 6X Human Organs Teaching Prop
£35.69
Amazon-marketplace.co.uk
Free Delivery

Anatomy Model for Eye Diseases Study, 6X Human Organs Teaching Prop
£14.49
Amazon-marketplace.co.uk
Free Delivery

Anatomy Model for Eye Diseases Study, 6X Human Organs Teaching Prop
£48.39
Amazon-marketplace.co.uk
Free Delivery

Anatomy Model for Eye Diseases Study, 6X Human Organs Teaching Prop
£23.09
Amazon-marketplace.co.uk
Free Delivery

Anatomy Model for Eye Diseases Study, 6X Human Organs Teaching Prop
£22.69
Amazon-marketplace.co.uk
Free Delivery
Human Diseases
£72.19
Whsmith.co.uk
Free Delivery

Thyroid Model Set Human Body Anatomy Replica of Thyroid Diseases Doctors Office for Educational Tool
£77.05
Amazon-marketplace.co.uk
Free Delivery

Retrotransposons And Human Disease: L1 Retrotransposons As A Source Of Genetic Diversity
£85.50
Whsmith.co.uk
Free Delivery

Larynx Functional Model, Life Size Anatomy Model Of Larynx Pharynx Model,Human Model Throat Model Anatomy for Diseases Study Larynx Anatomical Model
£14.99
Amazon-marketplace.co.uk
Delivery from £4.00
- 1
- 2
- 3
- 4
- 5
- next page
🤖 Ask ChatGPT
🛍️ What are the most important purchase criteria?
💰 Tell me the best deals!
📋 Create a short summary!
Informations about "human diseases: a"
With Pricehunter, you can compare prices online in order to find the offer that most fulfills your requirements "human diseases: a".
Based on your search criteria "human diseases: a", our price search engine found the lowest prices in 4 categories.
About "human diseases: a"
- Lowest prices found in 6 different mail order companies, including Amazon-marketplace.co.uk, Whsmith.co.uk, amazon.co.uk and rackhams.com.
- If you would prefer an item from a particular manufacturers, you can find 14 retailer for this product. If you have not yet made a decision, you can also filter your favourite producers and choose between 14 manufacturers.
- 14 different manufacturers offer the product - 3B Scientific, Oxford University Press, Taylor & Francis Group and Limtula, that you were looking for.
- Furthermore, other costumers also looked for the following product .
- With Pricehunter you are also spoilt for choice for colours. You can select your favourite from 6 colours. The article is most commonly ordered in the colour Grey.
How well did the information meet your expectations and assist you further?
Your responses remain anonymous and are used solely to improve our website. No personal data will be stored or shared with third parties.
Don't forget your voucher code:
Report Illegal Concerns
You are about to report a violation based on the EU Digital Services Act (DSA).